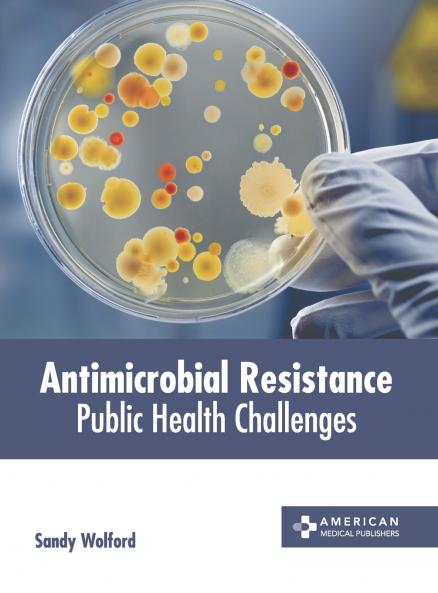
Antimicrobial Resistance

English
Hardback
₹13816
₹17102
19.21% OFF
(All inclusive*)
Delivery Options
Please enter pincode to check delivery time.
*COD & Shipping Charges may apply on certain items.
Review final details at checkout.
Looking to place a bulk order? SUBMIT DETAILS
Delivery Options
Please enter pincode to check delivery time.
*COD & Shipping Charges may apply on certain items.
Review final details at checkout.
About The Book
Description
Author
Antimicrobial Resistance (AMR) refers to a phenomenon wherein microorganisms such as bacteria viruses fungi and parasites change or mutate over time in such a manner that they do not respond to medicines. When microorganisms develop such resistance it makes the treatment of infections difficult which increases the risk of disease spread severe illness and death. AMR can be caused due to several factors such as inappropriate treatment prescription errors self-medication and the emergence of an increasing number of elderly and immunocompromised population. The overdose of antibiotics causes the resistant bacteria to survive and even multiply. Antimicrobial resistance can be acquired through five mechanisms which are the production of drug-inactivating enzymes modification of an existing target acquisition of a target by-pass system reduced cell permeability and drug removal from the cell. In order to control AMR certain actions should be taken into consideration that include running information campaigns for the consumers broadcasting information providing training for the healthcare professionals improving diagnostics for treatment decisions and issuing treatment guidelines etc. This book aims to shed light on some of the public health challenges of antimicrobial resistance. It presents researches and studies performed by experts across the globe. The extensive content of this book provides the readers with a thorough understanding of the subject.
Details
ISBN 13
9781639278879
Publication Date
-26-09-2023
Pages
-248
Weight
-745 grams
Dimensions
-216x280x15.88 mm